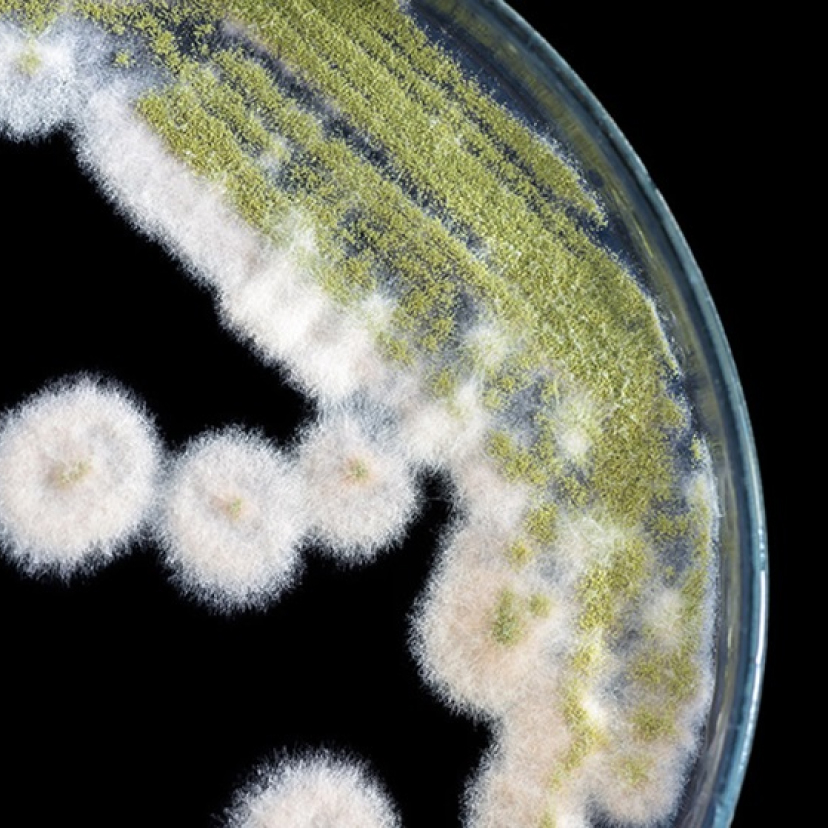
Nahaufnahme von weiß-grünem Schimmel.

Antike: Badehäuser

Außerdem gibt es Funde die beweisen, dass sogar die Toilettenanlagen sehr fortschrittlich waren. Beispielsweise fand man in den Ruinen einiger irakischer Paläste Toilettenräume mit Wasserspülung. In Griechenland entdeckten Archäologen reich verzierte Latrinenräume. Archäologische Funde von Toiletten, die über 5000 Jahre alt waren, wurden in Schottland, Indien, Italien, Griechenland und im Irak gemacht – im Grunde also auf der ganzen Welt. (1,2,3)
Oder vielleicht doch nicht so fortschrittlich?
Außerdem wurde das Toilettenpapier erst viel später erfunden, sodass sich die Menschen häufig mit Schwämmen oder den Händen abwischten. Dabei teilten sich in der Regel mehrere Bewohner einen Schwamm – eine äußerst unhygienische Praxis.
In der Antike gab es bereits erste Überlegungen, die menschlichen Exkremente über Flüsse oder einfache Kanalisationssysteme aus den großen Städten wie Rom herauszuleiten. Doch je nach Wetterlage führte dies zu neuen Problemen. Bei Überschwemmungen zum Beispiel kam alles wieder an die Oberfläche. In Dürrezeiten kam die Strömung zu Erliegen und die Flüsse verwandelten sich in stinkende Kloaken. Häufig wurden die Fäkalien einfach auf Wiesen und Felder verteilt. Auch das Trinkwasser war stark verschmutzt und mit Bakterien und Keimen belastet. Der Pest, die im Jahr 430 v. Chr. brach in Athen ausbrach, fiel etwa ein Viertel der Bevölkerung zum Opfer. Mit dem Untergang des Römischen Reiches im 5. Jahrhundert v. Chr. verschwand auch die Latrinenkultur. (4,5,6)

Schmutzige Zeiten: das Mittelalter

Innerhalb eines Zeitraums von wenigen Jahren tötete die Pest in drei Wellen etwa ein Drittel aller Europäer. Zwar gibt es keine genauen Zahlen, doch Schätzungen zufolge sind etwa 20 bis 50 Millionen Menschen daran gestorben. Ganze Dörfer wurden ausgelöscht. Die einzige Möglichkeit zur Eindämmung der hochansteckenden Krankheit war die Isolierung der Erkrankten und die Umsetzung von Quarantänemaßnahmen. Zur Verbesserung der hygienischen Bedingungen wurden zu dieser Zeit auch die ersten Gesetze zur „Sauberhaltung der Straßen“ verabschiedet. Doch der Pesterreger wurde erst im Jahr 1894 von dem Schweizer Arzt Alexandre Yersin entdeckt. (7)
Rokoko: mit Puder und Parfüm gegen Krankheitserreger
Bis in die erste Hälfte des 19. Jahrhunderts maß die Medizin dem Thema Sauberkeit und Desinfektion nur eine untergeordnete oder gar keine Bedeutung bei. Das bedeutete, dass sich Keime über ungewaschene Hände und nicht gereinigte Instrumente ungehindert in den Krankenhäusern ausbreiten konnten, sodass Blutvergiftung und Kindbettfieber zu den häufigsten Todesursachen der Patienten und Patientinnen wurden. (8,9)

Den Krankheitserregern auf der Spur: Ignaz Semmelweis

Semmelweis zog die richtige Schlussfolgerung, nämlich dass Ärzte gefährliche Krankheitserreger von den Leichen auf die Patientinnen übertrugen. Daher führte er verbindlich die Waschung mit Chlorkalk ein, und innerhalb von zwei Monaten sank die Sterblichkeitsrate auf der Station von 17 auf 1,2 Prozent. Leider wurden die Erkenntnisse von Semmelweis in der Medizin lange Zeit nicht berücksichtigt und die Ärzte in den Krankenhäusern setzten ihr Arbeit ohne Desinfektion fort. Semmelweis kämpfte viele Jahre für die Einführung der Händehygiene vor medizinischen Eingriffen, doch leider vergeblich. Schließlich wurde er aufgrund einer schweren Depression in eine staatliche Anstalt eingeliefert, wo er verstarb. Die Umstände seines Todes – angeblich Sepsis – wurden nie vollständig aufgeklärt. (10)
Vom Moloch zur Hygienemetropole: München
Pettenkofer konnte sein Können schon bald unter Beweis stellen, als einige Jahre später in München die Cholera ausbrach. Der junge Chemiker wurde schnell auf die schlechten hygienischen Bedingungen in der Stadt aufmerksam. Zu dieser Zeit gab es in München kein fließendes Trinkwasser, die Straßen waren voller Müll, und Fäkalien wurden einfach auf großen Plätzen gesammelt. Pettenkofer erkannte, dass die hygienischen Bedingungen in der Stadt und die Gesundheit ihrer Bewohner miteinander zusammenhingen, und machte aus der Hygiene eine wissenschaftliche Disziplin. Seine Studien und Bemühungen zur Verbesserung der städtischen Hygiene in München stießen zunächst auf Widerstand, zeigten aber schnell Wirkung. So gelang es ihm, aus dem stinkenden Moloch, das München zuvor gewesen war, eine hygienische Metropole mit Abwassersystemen und Hygieneplänen zu machen.
1883 wurde Pettenkofer für seine Verdienste das Adelsprädikat „von“ verliehen. Er sorgte dafür, dass bis 1900 fast 80 Prozent der Münchner Bevölkerung an die Kanalisation angeschlossen waren. In der Folge setzte sich das Wissen über Hygiene durch und verbreitete sich in ganz Europa. (11)

Die Bedeutung von Robert Koch, Louis Pasteur und Joseph Lister

Robert Koch entdeckte den Tuberkuloseerreger, spielte eine Schlüsselrolle bei der Eindämmung eines Cholera-Ausbruchs in Hamburg und wies auch andere Krankheitserreger wie die von Malaria und der Schlafkrankheit nach. Im Jahr 1891 wurde er zum Direktor des Preußischen Instituts für Infektionskrankheiten in Berlin ernannt, das später nach ihm benannt wurde. Koch erhielt den Nobelpreis für seine Tuberkuloseforschung und gilt zusammen mit seinem Pariser Kollegen Louis Pasteur als einer der Begründer der modernen Bakteriologie und Mikrobiologie sowie der Immunologie und Allergologie. (12,13,14)
Etwa zur gleichen Zeit wie sein deutscher Kollege erforschte Louis Pasteur Mikroorganismen, die durch Fäulnis und Gärung entstehen, und fand heraus, dass bestimmte Lebensmittel, wie z. B. Milch, durch Erhitzen haltbar gemacht werden können. So entstand das Verfahren, das wir heute als „Pasteurisierung“ bezeichnen. Darüber hinaus entwickelte Pasteur den ersten im Labor hergestellten Impfstoff gegen Geflügelcholera und später einen erfolgreichen Impfstoff gegen Milzbrand. (15,16)
Aufbauend auf Pasteurs Entdeckungen experimentierte Joseph Lister in Schottland mit einem antiseptischen Mittel auf Phenolbasis und schuf so die Grundlagen für die Sterilität. Die Verwendung von Gummihandschuhen, häufiges Händewaschen durch Ärzte und die Desinfektion von Händen, Instrumenten und Verbänden mit Phenol führten zu einem raschen Rückgang der Patientensterblichkeit. (17)
Die Entdeckung des Penicillins: ein medizinisches Wunder, das auf Unachtsamkeit zurückzuführen ist
Flemings Entdeckung gilt als ein weiterer Durchbruch in der Medizin. Zunächst erregten seine Publikationen keine Aufmerksamkeit, doch während des Zweiten Weltkriegs wurde er weltberühmt und Penicillin zu einer wahren Wunderwaffe. Fleming, der für seine Arbeit mit dem Nobelpreis ausgezeichnet wurde, zeigte Weitsicht, als er bereits 1945 voraussagte, dass Antibiotika ihre Wirksamkeit verlieren könnten, wenn sie nicht verantwortungsbewusst eingesetzt werden. Er sollte Recht behalten, denn der weit verbreitete Einsatz in der Massentierhaltung und die unnötige Verschreibung an Menschen haben zur Entstehung von antibiotikaresistenten Keimen geführt, die nur schwer zu bekämpfen sind. Dennoch sind Antibiotika in der heutigen Medizin nach wie vor unverzichtbar. (18)
Das erste industriell hergestellte alkoholische Händedesinfektionsmittel mit Pflegekomponenten: Sterillium®

Das schnell wirkende alkoholbasierte Sterillium® Virugard® wurde im Jahr 1995 als erstes hochwirksames viruzides Händedesinfektionsmittel in die Liste der getesteten und zugelassenen Desinfektionsmittel des Robert-Koch-Instituts aufgenommen. Im Jahr 2005 erhielt Sterillium® als erstes Händedesinfektionsmittel im medizinischen Bereich die Zulassung für die chirurgische Händedesinfektion mit einer verkürzten Einwirkzeit von nur 1,5 statt 3 Minuten. (19,20,21,22)
Die pflegenden Eigenschaften der Sterillium®-Produkte sind seit ihrer Einführung von großer Bedeutung. Die Hände sind das wichtigste Werkzeug der Chirurgen und ihre Gesundheit von größter Bedeutung. Im Jahr 2025 wurde Sterillium® von der ZEIT Verlagsgruppe zum vierten Mal zur „Marke des Jahrhunderts“ gewählt. (23)
Die Hygiene blickt auf eine lange Geschichte zurück und entwickelt sich ständig weiter. Heute haben wir bereits ein außerordentlich hohes Niveau erreicht. Durch Desinfektion von Krankenhäusern, medizinischen Instrumenten, Wunden und Händen sind wir in der Lage, Ärzte und Patienten zu schützen. Eine Errungenschaft, die besonders für Menschen mit geschwächtem Immunsystem wichtig ist. Zwar haben Desinfektionsmittel das Leben vieler Menschen bereits erleichtert haben, doch ihre Entwicklung ist noch nicht abgeschlossen. Eine wichtige Aufgabe für die Zukunft wird es sein, die Hygienebedingungen weltweit weiter zu verbessern und vor allem im globalen Süden bessere Bedingungen mit Zugang zu fließendem Wasser, Toiletten und Desinfektionsmitteln zu schaffen.
Sources:
[1]wikipedia.org/ Badekultur https://de.wikipedia.org/wiki/Badekultur
[2]planet-wissen.de/ Hygiene https://www.planet-wissen.de/gesellschaft/sauberkeit/hygiene/index.html
[3]planet-wissen.de/ Badekultur https://www.planet-wissen.de/gesellschaft/wellness/badekultur/index.html
[4]planet-wissen.de/ Geschichte der Toilette https://www.planet-wissen.de/natur/anatomie_des_menschen/verdauen/pwieklokulturheimlichoderungeniert100.html
[5]youtube.com/ MrWissen2go / Seuchen und Hygiene https://www.youtube.com/watch?v=JmD6DlJOdXo
[6]mdr.de/ Heute schon gewaschen? Kleine Geschichte der Reinlichkeit https://www.mdr.de/geschichte/zeitgeschichte-gegenwart/politik-gesellschaft/haendewaschen-hygiene-waschen-corona-100.html
[7]planet-wissen.de/ Der schwarze Tod – die Pest wütet in Europa https://www.planet-wissen.de/geschichte/mittelalter/leben_im_mittelalter/pwiederschwarzetoddiepestwuetetineuropa100.html
[8]wikipedia.org/ Hygiene https://de.wikipedia.org/wiki/Hygiene
[9]planet-wissen.de/ Barocke Hygiene – zwischen Pest, Parfüm und Puderperücken https://www.planet-wissen.de/geschichte/neuzeit/barock/barocke-hygiene-102.html
[10]aerzteblatt.de/ Ignaz Semmelweis: Retter der Mütter https://www.aerzteblatt.de/archiv/81908/Ignaz-Philipp-Semmelweis-Retter-der-Muetter
[11]planet-wissen.de/ Max von Pettenkofer – Hygiene für München https://www.planet-wissen.de/gesellschaft/sauberkeit/hygiene/pwiemaxvonpettenkoferhygienefuermuenchen100.html
[12]planet-wissen.de/ Robert Koch – Pionier der Mikrobiologie https://www.planet-wissen.de/gesellschaft/sauberkeit/hygiene/pwierobertkochpionierdermikrobiologie100.html
[13]rki.de/ Robert Koch: Der Mitbegründer der Mikrobiologie https://www.rki.de/DE/Content/Institut/Geschichte/Robert_Koch.html
[14]wikipedia.org/ Robert Koch https://de.wikipedia.org/wiki/Robert_Koch#Cholera
[15]elements.evonik.de/ Die Entwicklung der Hygiene https://elements.evonik.de/menschen-und-visionen/die-entwicklung-der-hygiene/
[16]wikipedia.org/ Louis Pasteuer https://de.wikipedia.org/wiki/Louis_Pasteur
[17]wikipedia.org/ Joseph Lister, 1. Baron Lister https://de.wikipedia.org/wiki/Joseph_Lister,_1._Baron_Lister
[18]geo.de/ Wie Alexander Fleming durch eine Schlamperei das Penicillin entdeckte https://www.geo.de/wissen/weltgeschichte/antibiotika-wie-alexander-fleming-durch-eine-schlamperei-das-30176284.html
[19]bode-chemie.de/ Bode Chemie GmbH https://www.bode-chemie.de/bode/geschichte.php
[20]sterillium.de/ Wie alles begann: 55 Jahre Sterillium®-Geschichte https://www.sterillium.info/de-at/stories-hub/writing-hygiene-history
[21]sterillium.de/ Der blaue Klassiker seit 55 Jahren https://www.sterillium.info/de-at/%C3%BCber-sterillium
[22]wikipedia.org/ Viruzid https://de.wikipedia.org/wiki/Viruzid
[23]management-krankenhaus.de/ Sterillium zur „Marke des Jahrhunderts“ gekürt https://www.management-krankenhaus.de/news/sterillium-zur-marke-des-jahrhunderts-gekuert
*Desinfektionsmittel vorsichtig verwenden. Vor Gebrauch stets Etikett und Produktinformationen lesen.
HWG-Pflichttexte
pflichttext_sterillium.pdf
pflichttext_sterillium_virugard.pdf